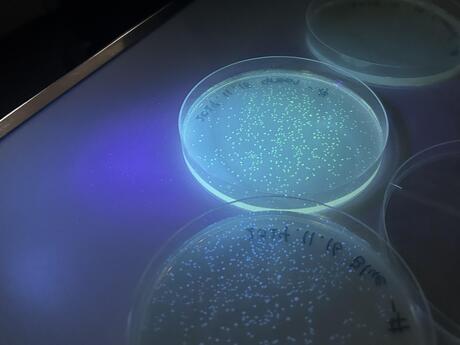

- HOME
- >
- 学校生活
- >
- 山城高校の一日
- >
- 京都府立大学文理融合型連携講座
京都府立大学文理融合型連携講座
2024/11/29
令和6年11月23日(土)、先週に引き続き、文理総合科2年生21名が京都府立大学を訪問し、田中 俊一 准教授(京都府立大学 生命環境学部 生命分子化学科 生命構造化学研究室)の遺伝子組換えに関わる特別講義を受け、前回の実験結果を観察しました。
大腸菌は、カナマイシンという抗生物質を含む培地では、生育できませんが、カナマイシン耐性の遺伝子をもつプラスミドを取り込むと、カナマイシンを含む培地で増殖できる大腸菌に形質転換します。
今回は、プラスミドを取り込ませていない条件と、薬剤耐性遺伝子を組み込んだプラスミドを取り込んだ条件、薬剤耐性遺伝子とあわせて蛍光タンパク質の遺伝子を組み込んだプラスミド(緑、青、赤のそれぞれ3種類)を取り込ませた条件の、5つの条件で培養しました。
実験は成功し、プラスミドを取り込ませていない条件では、大腸菌は生育できないため観察することができず、プラスミドを取り込ませた条件では、それぞれ大腸菌は増殖し、あわせて蛍光タンパク質を組み込んだ条件では、紫外線を当てることで蛍光を観察することができました。
生徒たちは、実際に蛍光を観察することができ、非常に楽しそうで、対照実験の意義等を質問するなど、大変有意義な時間でした。
また、実験後には、生命構造化学研究室に所属している本校卒業生が、研究室での成果としていくつか例を挙げ、自分たちのしている研究が実際にどのように社会に役立っているのかを紹介してくれました。
さらに、遺伝子組み換えに関して、倫理的視点だけでなく、進化論的視点や医療からの視点等、あらゆる視点から考え、議論したり、日頃の疑問等をたくさん質問することができ、生徒たちの科学的探究心が育まれました。